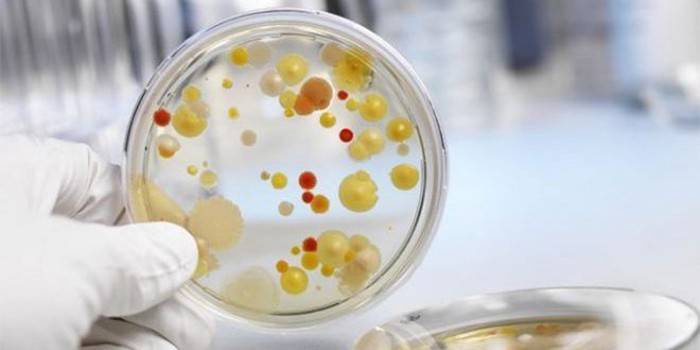

Lamisil z nechtovej huby - návod na použitie, forma uvoľnenia, zloženie, vedľajšie účinky, analógy a cena
Podľa návodu na použitie patrí Lamisil do nechtovej plesne do kategórie liekov na báze terbinafínu. Liek je dostupný v niekoľkých formách, ktoré sa líšia spôsobom, akým sa používajú. Každá z nich sa používa v určitom štádiu choroby. Je veľmi ľahké zachytiť spóry huby, najmä pri oslabenom imunitnom systéme. Podľa recenzií je účinným prostriedkom proti tejto patológii Lamisil na nechty. Na dosiahnutie tohto výsledku je dôležité poznať návod na použitie lieku.
Čo je liek Lamisil
Onychomykóza je choroba, ktorá prináša človeku veľa nepríjemností. V počiatočnej fáze nie je patológia veľmi nebezpečná, ale v zanedbanom stave môže spôsobiť mnoho komplikácií. V takýchto prípadoch sa liečba často uskutočňuje pomocou chirurgického zákroku. Aby sa stav nezhoršoval, je potrebné včas zahájiť terapiu proti plesniam. Zo všetkých antimykotík má Lamisil dobré recenzie. Hlavnou vlastnosťou lieku je deštrukcia bunkových membrán huby.
Čo pomáha
Antimykotická lieková terapia sa používa na liečbu plesňových infekcií, nielen nechtov, ale aj kože alebo vlasov. Hlavnou oblasťou aplikácie je liečba onychomykózy - nechtovej plesne na rukách a nohách. Tento liek sa tiež používa na liečbu viacfarebných lišajníkov, dermatomykózy nôh, trupu a plesňových infekcií pokožky hlavy.Ak budete postupovať podľa návodu na použitie čo najjasnejšie, môžete sa rýchlo zbaviť huby. Výhody Lamisilu z nechtovej huby sú:
- plný súlad s medzinárodnými normami;
- zabezpečenia;
- možnosť ošetrenia mnohých kmeňov huby;
- rýchla a účinná eliminácia patogénu infekcie.

Zloženie liečiva
Výhodou lieku je to, že je k dispozícii v niekoľkých formách. Účinnou zložkou každej z nich je terbinafín hydrochlorid. Ďalšie látky závisia od formy uvoľňovania. Zloženie lamisilu z nechtovej huby:
|
Uvoľňovací formulár |
Koncentrácia účinnej látky - terbinafín hydrochlorid |
Pomocné komponenty |
|
tablety |
250 mg |
oxid kremičitý; škrobový glykolát sodný; metylhydroxypropylcelulóza; stearát horečnatý. |
|
sprej |
10 mg v 1 ml |
čistená voda; etylalkohol; makrogol 400; cetostearyléter; propylénglykol |
|
masť |
10 mg v 1 ml |
hydroxid sodný; čistená voda; polysorbát 60; sorbitan stearát; cetyl, stearový, benzylalkohol; izopropylmyristát; cetilizovaný palmitát. |
|
lak |
10 mg na 1 ml |
alkohol; olejové extrakty. |
|
Riešenie Lamisil UNO |
10 mg na 1 ml |
kopolymér kyseliny akrylovej; triglyceridy; etanol. |
Uvoľňovací formulár
Dnes je liek k dispozícii takmer vo všetkých možných formách. Každá z nich je predpísaná na určitú plesňovú infekciu. Lekár môže predpísať tieto formy prepustenia:
- tablety - majú bielo-žltú alebo bielu farbu, drsný povrch, okrúhly, bikonvexný, s rizikom a fazetou, obsahujú 7 alebo 14 kusov v blistroch;
- sprej - predstavuje bezfarebnú priehľadnú tekutinu so svetlo žltým odtieňom a charakteristickým zápachom, je k dispozícii v polyetylénových fľašiach vybavených striekacou špičkou, každá po 15 alebo 30 ml;
- masť - homogénna biela hmota so slabým zápachom a viskóznou konzistenciou je obsiahnutá v hliníkových tubách s objemom 15 alebo 30 g;
- lak - predáva sa v súpravách, má rôzne farby, je k dispozícii v 2,5 ml fľašiach, vytvára na nechte ochranný film;
- roztok - predstavovaný viskóznou, bezfarebnou látkou s vôňou etanolu, balený v hliníkových skúmavkách po 4 g.
Mechanizmus účinku
Pri požití v pokožke, vlasoch a nechtoch sa hromadí koncentrácia, ktorá je potrebná na zabezpečenie fungicídneho účinku. Droga má široké spektrum účinnosti a je určená na vonkajšie použitie. Terbinafín neovplyvňuje metabolizmus hormónov a iných liekov, pretože neovplyvňuje systém cytochrómu P540.
Terbinafín je jedným zo syntetických antimykotík alylamínov. Takéto látky sú veľmi účinné proti mnohým plesniam, ktoré spôsobujú choroby nechtov, vlasov a pokožky. Ich zoznam obsahuje tieto mikroorganizmy:
- Kvasinky Candida (Candida albicans) a Pityrosporum;
- Epidermophyton floccosum;
- Trichophyton (Trichophyton);
- Microsporum (Microsporum canis).
Terbinafín vykazuje v nízkych koncentráciách fungicídny účinok proti dermatofytom, množstvu dimorfných húb a plesní. V prípade kvasiniek vykazuje liečivo fungistatickú aktivitu. To znamená, že látka pri vysokej koncentrácii ničí nielen hubové membrány, ale tiež bráni ich ďalšej reprodukcii. Terbinafín špecificky ovplyvňuje enzýmy húb. Látka v skorom štádiu inhibuje biosyntézu sterolov v nich. Kvôli nedostatku ergosterolu a akumulácii vo skvaléne odumierajú.
Indikácie pre použitie
Pre určité plesňové infekcie sú predpísané rôzne formy uvoľňovania. Indikácie pre systémovú tabletovú terapiu sú:
- formy onychomykózy spôsobené hubami dermatofytov;
- mykózy pokožky hlavy;
- plesňové infekcie kože, vrátane dermatomykózy dolných končatín a trupu, huby nôh;
- infekcie spôsobené hubami rodu Candida.
Lamisil z nechtov v tabletách nie je predpísaný na liečbu viacfarebného lišajníka. Droga vo forme spreja, krému, roztoku a laku sa predpisuje na tieto choroby:
- vyrážka z plienok spôsobená plesňami;
- inguinálna epidermofytóza;
- prevencia a liečba mykóz chodidiel;
- poškodenie huby hladkej pokožky;
- viacfarebný lišajník vyvolaný niektorými dimorfnými hubami.
Funkcie použitia počas tehotenstva
Pokiaľ ide o použitie Lamisilu u tehotných žien, počet štúdií je nedostatočný. Z tohto dôvodu môže lekár predpísať liek počas tohto obdobia. Odborník určí, do akej miery očakávaný prínos použitia prevyšuje potenciálne riziko. Laktácia v čase liečby liekom by sa mala prerušiť. Po ukončení liečby sa môže znovu začať.
Použitie v detstve
Výhodou tejto drogy je, že sa môže používať v detstve, ale existujú určité obmedzenia týkajúce sa užívania určitých foriem uvoľňovania drogy:
- tablety sú povolené pre deti staršie ako 2 roky;
- Sprej, roztok a krém sa odporúčajú používať deťom starším ako 12 rokov.

Návod na použitie nechtov
Dĺžka liečby pri každej forme liečby závisí od choroby a od individuálnych lekárskych predpisov. Liek má na použitie niekoľko špeciálnych indikácií. Ak sa pacient začne počas liečby sťažovať na závraty, liek sa musí vysadiť. To isté platí pre vývoj alergickej reakcie. Ak je lézia veľká, mali by ste si kúpiť 30 ml sprej. Liečba by sa nemala prerušiť, inak sa môže infekcia obnoviť. Nie sú k dispozícii žiadne údaje o vplyve lieku na schopnosť viesť vozidlo.
tablety
Dávka tabliet pre dospelých pacientov je 250 mg denne. U detí závisí množstvo predpísaného lieku od telesnej hmotnosti:
- u dojčiat s hmotnosťou do 20 kg je uvedená dávka 62,5 mg za deň;
- s hmotnosťou 20 až 40 kg - 125 mg;
- ak telesná hmotnosť presahuje 40 kg - 250 mg.
Priebeh liečby sa môže líšiť. Pri dermatomykóze nôh to trvá asi 2-6 týždňov. Pri iných chorobách je trvanie liečby nasledujúce:
- v prípade mykózy pokožky hlavy - 4 týždne;
- s onychomykózou - 6 - 12 týždňov;
- s kožnou kandidózou, dermatomykózou nôh alebo trupu - 2 - 4 týždne.
Masť a krém
Na lokálne ošetrenie sa používa liek vo forme masti alebo krému. Droga sa aplikuje na pokožku 1-2 krát denne. Odporúčania pre použitie sú nasledujúce:
- pred aplikáciou musí byť pokožka očistená a osušená;
- potom môžete rozotrieť tenkú vrstvu krému na lézie a zdravé oblasti v okolí;
- jemne trieť, kým sa úplne nevstrebáva;
- ak je potrebné vyliečiť vyrážky z plienok, potom musí byť lézia zakrytá gázou.

Frekvencia aplikácie a trvanie liečby Lamisilom vo forme krému sú tiež určené v závislosti od choroby. Pri dermatomykóze sa zastavenie aplikuje raz denne počas 1 týždňa. Priebeh liečby iných chorôb sa líši:
- 2 týždne, 1 - 2 krát denne - s svrbivou pokožkou a prasklinami spôsobenými plesňami;
- 2 týždne, 1 - 2 krát denne - s viacfarebnými lišajníkmi;
- 1-2 týždne, 1-2 krát denne - s kandidózou kože.
Sprej a mlieko
U dospelých pacientov je liek vo forme spreja predpísaný na použitie 1 až 2-krát denne. Pred použitím je potrebné pokožku očistiť a vysušiť. Sprej sa nastrieka na léziu a priľahlé malé zdravé časti kože. Je potrebné aplikovať také množstvo liečiva, aby stačilo na zvlhčenie pokožky. Dĺžka liečby je určená chorobou:
- s viacfarebnými lišajníkmi - 2 krát denne počas 1 týždňa;
- s inguinálnou epidermofytózou, vyrážkami z plienok a dermatomykózou - týždeň, jeden sprej denne.
lak
Tento formulár má niekoľko funkcií aplikácie. Nástroj je aplikovaný nielen na postihnuté nechty, ale aj na zdravé. Laková súprava tiež obsahuje pilníky na nechty na jedno použitie na odstránenie drsného povrchu nechtovej platne. Užívajte liek na dlhú dobu - asi šesť mesiacov. Návod na použitie je nasledovný:
- kúpte sa nechtom manganistanom draselným;
- použitie pilníka na odstránenie drsného povrchu nechtových platní;
- s vatovým tampónom namastite necht alkoholovým tampónom, nakrájajte ho na čo najkratšiu dobu;
- naneste tenkú vrstvu laku, počkajte na zaschnutie.
Liečba plesňových infekcií lakom bude účinná iba pri dodržaní určitých pravidiel. Hlavné odporúčania v tomto prípade sú:
- Vyhnite sa nanášaniu laku na nechtové lôžko;
- Nezastavujte priebeh liečby v predstihu;
- navlhčený ošetrený povrch počas dňa;
- nedotýkajte sa okrajov fľaše kefou;
- Nepoužívajte ten istý súbor na zdravé a choré nechty.

Koľko je Lamisil
Každá forma uvoľňovania liečiva má určitú cenu. Závisí to od výrobcu a miesta nákupu lieku. Liek si môžete kúpiť v bežnej alebo online lekárni. V druhom prípade je možné objednať si liek s donáškou do domu. Liek je potrebné uchovávať na mieste neprístupnom pre deti, kde teplota nepresahuje 30 stupňov. Približné náklady na Moskvu a Petrohrad sú uvedené v tabuľke:
|
Miesto nadobudnutia |
Uvoľňovací formulár |
Množstvo, objem |
Cena, rubľov |
|
Zdravotná zóna |
Dermgel 1% |
15 g |
487 |
|
Krém 1% |
15 g |
479 |
|
|
sprej |
30 ml |
719 |
|
|
1% roztok |
4 g |
762 |
|
|
tablety |
14 kusov |
1969 |
|
|
Europharm |
Krém 1% |
30 g |
899 |
|
Krém 1% |
15 g |
550 |
|
|
1% roztok |
30 g |
899 |
|
|
Dermgel 1% |
15 g |
620 |
|
|
tablety |
14 kusov |
2350 |
|
|
Lekáreň IFC |
Dermgel 1% |
15 g |
682 |
|
sprej |
30 ml |
896 |
|
|
Krém 1% |
30 g |
939 |
|
|
tablety |
14 kusov |
2406 |
Vedľajšie účinky
Väčšina pacientov, podľa ich posudkov, dobre lieči Lamisil, ale stále sa môžu vyskytnúť vedľajšie účinky. Negatívna reakcia na tento liek ovplyvňuje rôzne telesné systémy:
- Imunitný systém. Zaznamenávajú sa anafylaktoidné reakcie a lupus erythematodes.
- Kožné reakcie. Prejavujú sa prejavmi žihľavky, vyrážky a niekedy aj exacerbácie psoriázy a vypadávania vlasov.
- Obehový systém. Pozorujú sa poruchy zloženia krvi - neutropénia, trombocytopénia, agranulocytóza.
- Muskuloskeletálny systém. Nežiaduce účinky sa prejavujú pri myalgii a artralgii.
- Tráviaci systém. Droga môže spôsobiť zníženie chuti do jedla, hnačku, bolesť brucha, pocit preplnenia žalúdka a dyspepsiu.
- Nervový systém. Po podaní lieku sa môžu vyskytnúť poruchy chuti, bolesti hlavy a zriedkavejšie závraty, parestézia a hypestézia.
Pri predávkovaní liekom je zaznamenané zvýšenie vedľajších účinkov. Pacient sa môže sťažovať na nevoľnosť, bolesti hlavy, závraty a bolesť v epigastriu. Liečba by mala byť symptomatická. Pacientovi by sa malo podať aktívne uhlie, vypláchnite žalúdok a ak existujú ďalšie znaky predávkovania, podajte viac liekov na symptomatickú liečbu.

kontraindikácie
Tí, ktorí trpia ochorením pečene, a dokonca aj tí, ktorí nie sú postihnutí, môžu mať po aplikácii Lamisilu hepatotoxicitu. Z tohto dôvodu musíte vedieť, že ak máte nevoľnosť, únavu, bolesť v správnom hypochondriu, žltačku a tmavý moč, musíte ísť k lekárovi. Absolútne kontraindikácie užívania drogy sú:
- neznášanlivosť alebo precitlivenosť na základné lieky;
- chronické alebo akútne ochorenie pečene;
- zhoršená funkcia obličiek.
Interakcia s inými liekmi
Plazmatický klírens terbinafínu sa zvyšuje pri jeho metabolických induktoroch a spomaľuje pôsobením inhibítorov cytochrómu P540. Ak je potrebné použiť Lamisil na nechtové huby, potom sa oplatí upraviť dávkovanie lieku.Ďalšie vlastnosti interakcie:
- Cytemidín zvyšuje účinok a zvyšuje koncentráciu terbinafínu v plazme a znižuje klírens o 33%;
- terbinafín zvyšuje účinok a zvyšuje koncentráciu kofeínu, ktorého klírens sa pri intravenóznom podaní znižuje o 19%;
- oslabuje účinok cyklosporínu a znižuje jeho koncentráciu v plazme;
- klírens desipramínu počas užívania terbinafínu je znížený o 82%;
- koncentrácia a účinok terbinafínu znižuje rifampicín.
analógy
Ak sa Lamisil z nejakého dôvodu nezmestí, potom je vždy ľahké zvoliť analógy lieku s podobným účinkom:
- terbinafín;
- Termikon;
- Terbizil;
- Terbiks;
- ekzifin;
- Lotseril;
- ekzoderil;
- Binafin;
- Terbifin.
video
 Lamisil: forma lieku, účinky použitia. Lamicon alebo Lamisil?
Lamisil: forma lieku, účinky použitia. Lamicon alebo Lamisil?
recenzia
Natalia, 32 rokov Dlho som sa snažil liečiť huby ľudovými metódami, ale nič nepomohlo. Napriek tomu som sa rozhodol ísť k lekárovi a urobiť testy. Špecialista predpísal Lamisil na nechtové huby. Ona podstúpila 2-týždňovú liečbu, po ktorej sa stav doštičiek výrazne zlepšil. Ich farba už nebola tak žltá. Keď som zasekol postihnuté okraje, zdravé nechty rástli.
Julia, 26 rokov Často navštevujem telocvičňu a bazén, preto na prevenciu používam lak Lamisil. Aplikujem to každý týždeň. Lekár povedal, že ho môžete používať aj pod kozmetickým lakom. Účinok je skutočne viditeľný. Predtým som pozoroval pravidelnú stratifikáciu nechtov na nohách a po použití laku vyzerali zdravo, dokonca sa objavil lesk.
Christina, 39 rokov Po odpočinku v zahraničí som si všimol problémy s nechtami na rukách a nohách: získali žltý odtieň a koža v blízkosti začala zčervenať a bolieť. Potom, čo som išiel k lekárovi, začal som používať krém Lamisil. Rozmazala ho nielen na nechty, ale aj na pokožku v okolí. Po 6 týždňoch sa stav zlepšil, ale liek som používal na prevenciu ďalších 7 dní.
